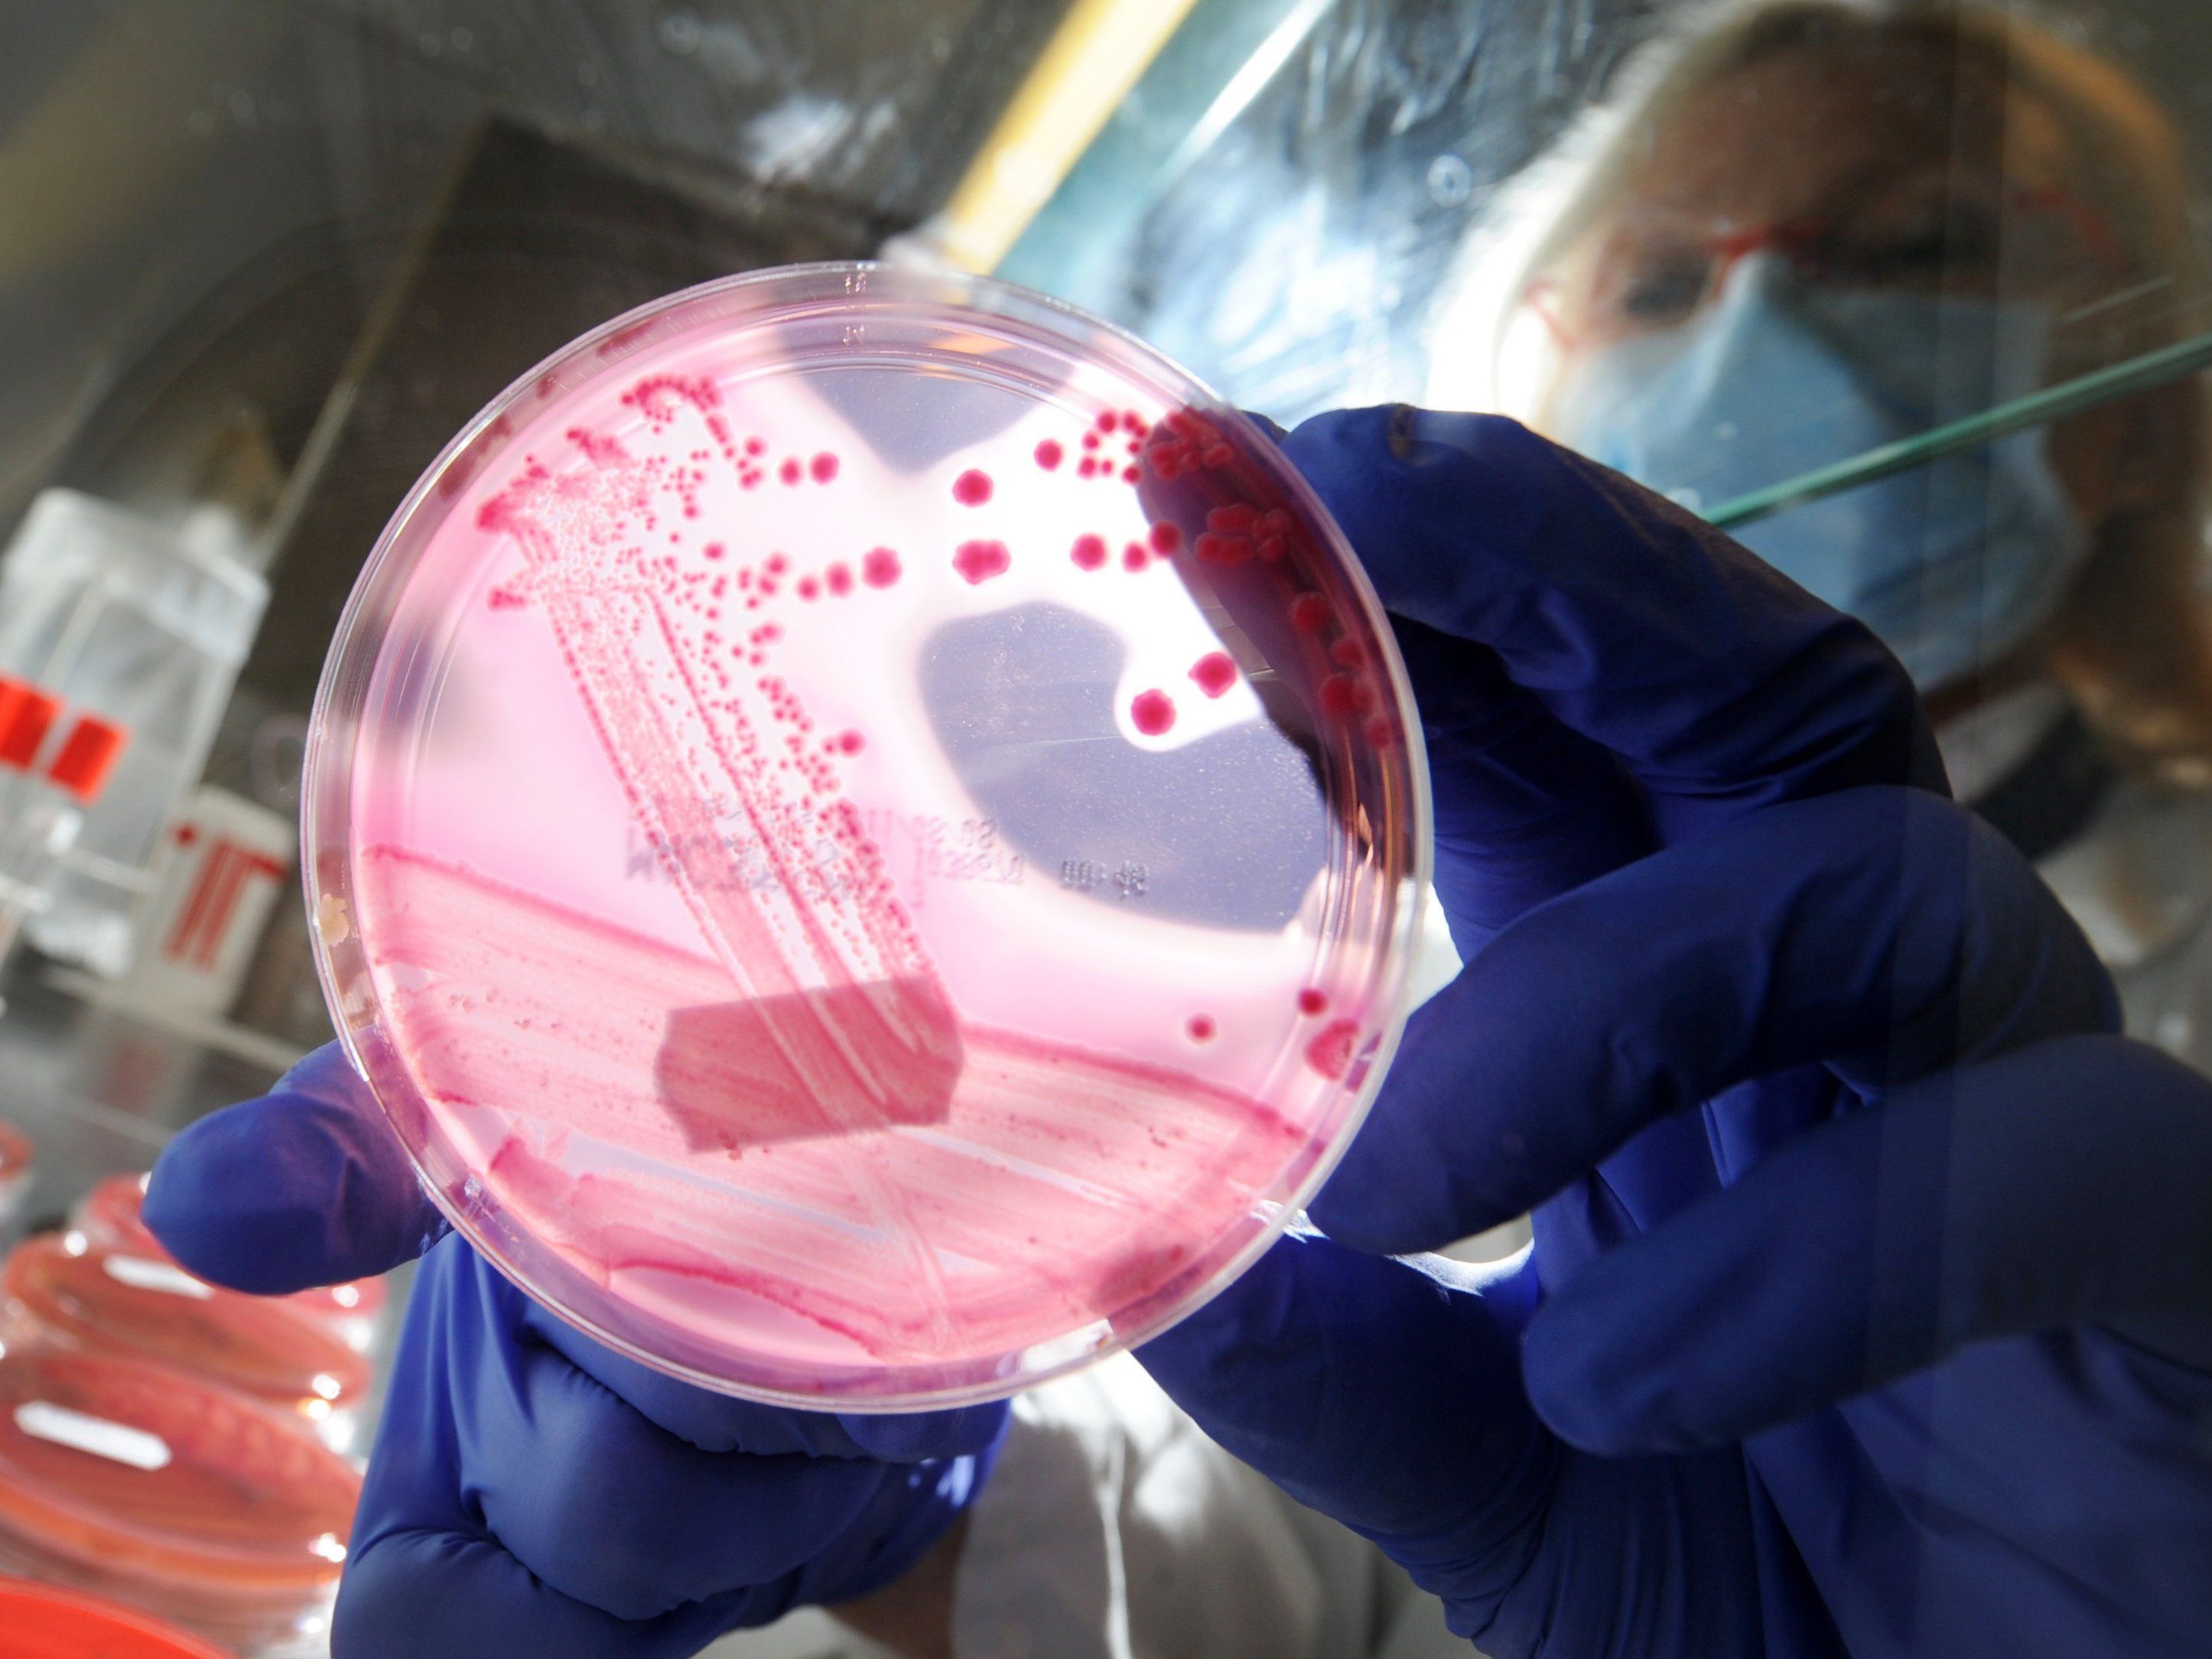

Salmonellen-Verdacht bei Tiefkühl-"Ente mit Orangen-Apfelfüllung"
Produkte Vorsorglich aus dem Handel genommen.
©dpa
Im Zuge von internen Qualitätskontrollen wurden bei einer Probe eines Tiefkühlenten-Produkts ("Ente mit Orangen-Apfelfüllung, 2000g") - bei Lidl im Handel Salmonellen vom Stamm typhimurium nachgewiesen. Lidl Österreich hat alle Produktionschargen vorsorglich aus dem Verkauf genommen, teilte der Konzern am Mittwoch mit.
Bei Einhaltung der auf der Verpackung angebrachten Küchenhygiene- und Durcherhitzungshinweise bestehe üblicherweise keine Gefahr für Konsumenten, hieß es in der Mitteilung. Man bitte alle Kunden, die das Produkt gekauft haben, um Rückgabe in einer der Filialen (Rückerstattung auch ohne Kaufbeleg; Lidl-Österreich-Kundenservice – Telefonnummer 0800/500 810).
Durch Hitzeeinwirkung sterben Salmonellen bei 55 Grad Celsius nach einer Stunde, bei 60 Grad nach einer halben Stunde ab. Als gesicherte Keimabtötung gilt ein Erhitzen auf über 70 Grad Celsius für mindestens 15 Sekunden. Produzent der Tiefkühlenten ist die SK-Meat Vertriebs. GmbH (D-49685 Emstek).
(APA)